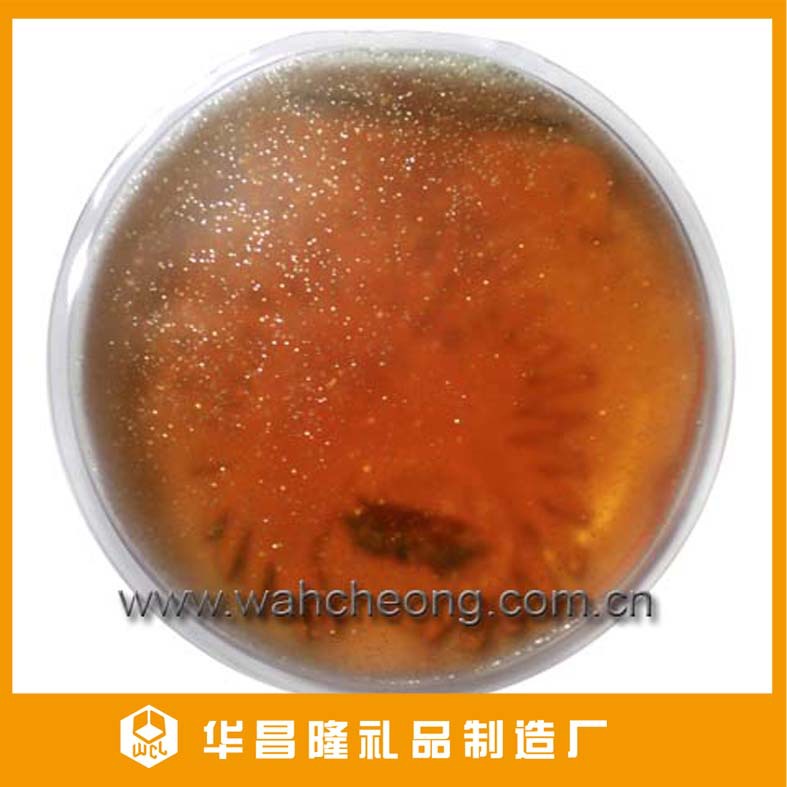

'

产品使用方法:
1.掰曲金属片,液体发热包即可产生热量,并逐渐出现结晶状态,用手搓揉发热包3~5秒左右,使发热包散热均匀,即可放在需要保暖的部位。
2.发热包的最高温度可达50℃左右,小心烫伤皮肤。(使用前可以裹上薄毛巾)
3.将发热包放入口袋或用毛巾包裹,可延长发热包时间。
4.当发热包完全结晶成固体后,放进热水煮大约5~15分钟(先在锅底垫上布或毛巾,再放入发热包),待结晶体完全融化成液体并冷却后,即可按以上步骤循环使用

注意事项:
1.请勿置于微波炉加热
2.不可食用
3.禁止插入异物或用锐器刺破产品
4.儿童必须在成人指导下使用




丝印部
干净整洁的工做环境、有专业的印刷队伍,每个环节都有人员检查。



柯印:
四色印刷机,套印准确,图案丰富,印刷精细,色彩鲜艳

定形切边:
精确开模,切边,电压,封口,周期短,效率高





华昌隆礼品制造厂(Wah Cheong Lung Gift Factory) 成立于2001年8月,位于交通便利、配套齐全、充满活力与朝气的深圳市龙岗区。是一家集开发,生产,销售为一体的综合性企业,本公司已通过BSCI 和 ISO9001国际认证,是全球范围内香味发热包、眼睛加布发热包、奶瓶发热包及各种类型发热包等产品研发和生产经营的领先者之一。
工厂车间设有开发工程部、模具部、制板部、电压部、丝印部、包装部、仓库部、开料部等。拥有先进的生产设备,认真负责的业务与高素质的管理人才及技术人员。快速灵活的制度,使得我们打板速度快、品质稳定、交货准时,为高品质的产品提供有力的保证。同时,工厂采用先进的管理模式,着重为每一位员工提供舒心、安全的工作和生活环境及良好的发展机会。凭借无法释怀的理想与创作激情,我们走出了一条以创意领先,勇于创新的道路。
因我司产品款式很多,详细价格各不相同,成交价以我司正式报价为准.
'